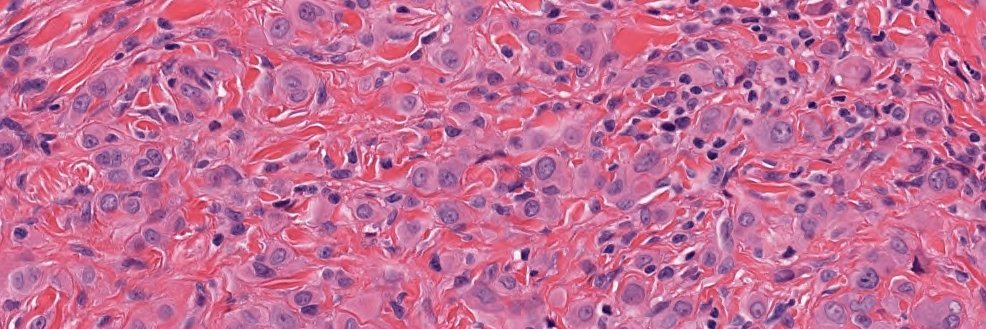
Anurag Sharma banner

Sabitlenmiş Tweet

58 F skin lesion on left occipital scalp. No tumor anywhere else in the body #dermpath #dermtwitter #BSTpath #PathTwitter @HENRYY_MD @vhnguyenmd @Coluchkaaaaa @DrGeeONE @JamesSampson123 @Meghna0630 @PoojaSMD @MELanocyteMD @forthejon




English